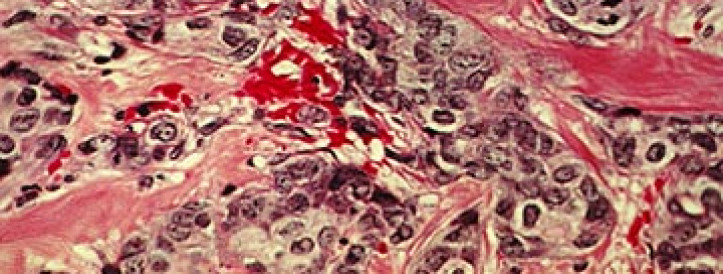
U.S. study will test whether drug combinations can wipe out tumors

Preprint by author Richard Murdoch Montgomery presents a radical reassessment of scientific validation processes, arguing that traditional peer review has become an outdated, inefficient, and ultimately flawed mechanism for ensuring research quality.
The National Science Foundation (NSF) said today it would sharply reduce overhead payments to universities receiving its grants. Federal judges have temporarily blocked earlier attempts by the National Institutes of Health (NIH) and the Department of Energy (DOE) to lower reimbursement of so-called indirect costs to 15%, and observers expect NSF’s identical proposal to meet the same fate.
A researcher at the Environmental Protection Agency (EPA) added their underage child as a coauthor on a paper after the manuscript cleared the agency’s internal review, an investigation found. The revelation, which calls into question the EPA’s process for reviewing papers, was among several highlighted by the agency’s Office of Inspector General in an April 8 report, which is redacted for names and identifying details.
Read more: A "stupid mistake": EPA researcher added their underage child as an author on manuscript
The chief editors of the journal Sedimentology have resigned, along with nearly a third of its associate editors, as the society running the title amended its publishing contract. The International Association of Sedimentologists (IAS), a scientific society based in Belgium, owns the journal and contracts with Wiley to publish it. "We, like the [contributing editors] who resigned, believe that the move to a Wiley-led model, and the loss of all internal editorial assistance is extremely detrimental to the future of Sedimentology", the resignation letter stated, citing changes to the role of the journal’s longtime editorial office manager.
The Journal of Intelligent and Fuzzy Systems (JIFS) had retracted 1,561 articles as part of a cleanup operation on likely paper mill activity. The journal, which Sage acquired in November 2023 when it bought IOS Press, had previously retracted a batch of 49 articles in October 2021. That brings its retraction total up to 1,610. The journal charges a fee for all accepted papers; separate fees apply for open access.
Read more: Journal collected $400,000 from papers it later retracted
Scientific sleuth Anna Abalkina uncovered several issues with Science of Law, which she details in a post. Besides editors and editorial board members who cannot be verified and don’t seem to exist, the journal’s history doesn’t match its publication record, early articles show signs of fabrication, and its publisher data in Scopus doesn’t match that in Crossref. Despite this, Scopus added the journal to its index last year.
Read more: Elsevier removes journal from Scopus after Retraction Watch inquiry
The managing editors and entire editorial board of Mathematical Logic Quarterly, a Wiley title, have resigned, citing “unilateral decisions” by the publisher “that affected the editorial process.”
Read more: Math journal editors resign to launch open-access title ‘free from pressure or influence’
Last year, Scientific Reports retracted a paper comparing the condition, which the authors dubbed Middle East Pain Syndrome, to rheumatoid arthritis for failing to establish a clear distinction between the two ailments. The new article, published in January 2025 in BMC Rheumatology with two overlapping authors, compares MEPS to fibromyalgia, claiming it is distinct for its "hand tufts spur-like excrescences".
Read more: A second article describing new pain syndrome under scrutiny
The threat hanging over South African HIV/AIDS researchers for the past week has become a reality: President Donald Trump’s administration this afternoon began terminating or putting on hold their grants from the U.S. National Institutes of Health (NIH). The cuts appear in part linked to an escalation of NIH efforts to terminate grants, at least some of which the government has decided have components of diversity, equity, and inclusion (DEI).
Read more: ‘Orchestrated assault’: New tsunami of NIH grant cuts hits South Africa hard